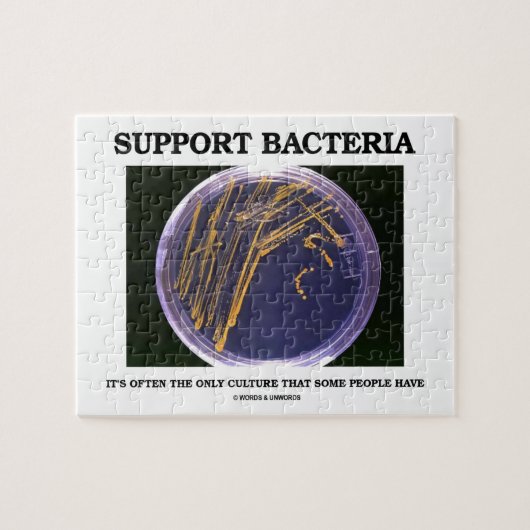
Steun voor bacteriën vaak slechts cultuur Sommige  Legpuzzel (Horizontaal)

Over Puzzels
Aangeboden door
Over dit ontwerp
Steun voor bacteriën vaak slechts cultuur Sommige Legpuzzel
Geen bacterioloog, microbioloog of bioloog nodig om van dit tong-in-cheek wetenschappelijk gezegde te genieten dat een agar bord met bacteriële kolonies omvat. Het gezegde zegt het allemaal: "Steun voor bacteriën - het is vaak de enige cultuur die sommige mensen hebben". Maak dat anderen een dubbelspel doen met al die geschenken van geek humor gezegde over cultuur!
Ontwerp van international designer
Klant beoordelingen
5.0 van 5 sterren beoordeling1 aantal beoordelingen
1 Reviews
Beoordelingen voor identieke producten
5 van 5 sterren beoordeling
Door L.22 januari 2020 • Geverifieerde aankoop
27,9 x 35,5 cm, 252 stukjes
Zazzler recensent programma
Snelle levering , goede kwaliteit
Ik mis een goede voorbeeld foto.
Nu alleen een hele kleine foto van het onderwerp op de deksel.
Het zou prettig zijn als er een grotere foto bijgevoegd zou worden. Heldere afbeelding .
Ben nog bezig met leggen
Tags
Andere Info
Product ID: 116457635712252332
Ontworpen op: 5-10-2015 13:48
Rating: G
Recent bekeken items